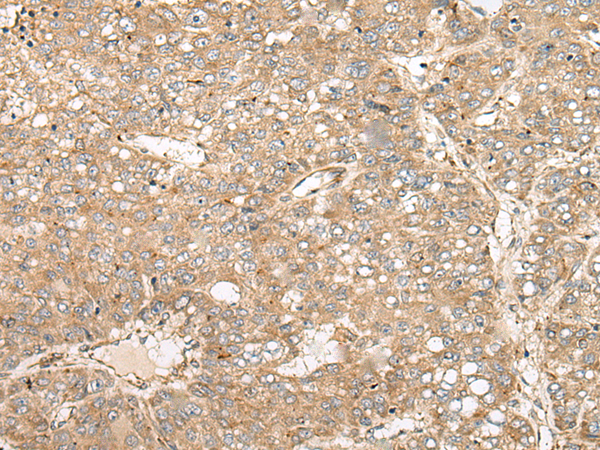

中文名稱: 兔抗COA7多克隆抗體
|
Background: |
The cytochrome c oxidase (COX) family of proteins function as the final electron donor in the respiratory chain to drive a proton gradient across the inner mitochondrial membrane, ultimately resulting in the production of water. COA7 (cytochrome c oxidase assembly factor 7), also known as RESA1, SELRC1 or C1orf163, is a 231 amino acid mitochondrial protein that belongs to the hcp beta-lactamase family. Consisting of five Sel1-like repeats, COA7 may be associated with respiratory chain assembly. COA7 is encoded by a gene located on human chromosome 1p32.3. Chromosome 1 is the largest human chromosome spanning about 260 million base pairs and making up 8% of the human genome. There are about 3,000 genes on chromosome 1, and considering the great number of genes there are also a large number of diseases associated with chromosome 1. Notably, the rare aging disease Hutchinson-Gilford progeria is associated with the LMNA gene, which encodes lamin A. When defective, the LMNA gene product can build up in the nucleus and cause characteristic nuclear blebs. The mechanism of rapidly enhanced aging is unclear and is a topic of continuing exploration. |
|
Applications: |
ELISA, WB, IHC |
|
Name of antibody: |
COA7 |
|
Immunogen: |
Full length fusion protein |
|
Full name: |
cytochrome c oxidase assembly factor 7 (putative) |
|
Synonyms: |
RESA1; SELRC1; C1orf163 |
|
SwissProt: |
Q96BR5 |
|
ELISA Recommended dilution: |
5000-10000 |
|
IHC positive control: |
Human liver cancer and human lung cancer |
|
IHC Recommend dilution: |
40-200 |
|
WB Predicted band size: |
26 kDa |
|
WB Positive control: |
HEPG2 and HL-60 cell lysates |
|
WB Recommended dilution: |
500-2000 |

購(gòu)物車
購(gòu)物車 幫助
幫助
 021-54845833/15800441009
021-54845833/15800441009
